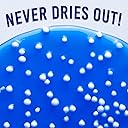
Thumbnail 5

🌀 Crackle, pop, and create your way to calm with Crazy Aaron’s Thinking Putty!
Crazy Aaron's Thinking Putty - Crackle’n Kracken is a multi-color, non-sticky sensory putty designed for kids and adults. Housed in a convenient 4-inch tin, this 90g putty never dries out and offers endless creative and stress-relief play. Made in the USA from non-toxic silicone, it supports sensory development and fine motor skills while delivering a mess-free, tactile experience.






| ASIN | B0BJNFDXKR |
| Additional Features | Non Sticky |
| Age Range Description | Kids and Grown ups |
| Best Sellers Rank | #190,355 in Toys & Games ( See Top 100 in Toys & Games ) #809 in Slime & Putty Toys |
| Brand Name | Crazy Aaron's |
| Color | Blue,white |
| Container Type | Can |
| Customer Reviews | 4.3 4.3 out of 5 stars (245) |
| Educational Objective | Creative Thinking |
| Global Trade Identification Number | 00810066953680 |
| Included Components | Colorant |
| Item Dimensions | 7.68 x 1.38 x 4.13 inches |
| Item Form | Foam,Putty,Putty® |
| Item Type Name | Thinking Putty |
| Item Volume | 96 Milliliters |
| Item Weight | 0.19 Pounds |
| Manufacturer | Crazy Aaron's |
| Manufacturer Maximum Age (MONTHS) | 1186.0 |
| Manufacturer Minimum Age (MONTHS) | 36.0 |
| Manufacturer Part Number | KK020 |
| Material Type | Non-toxic silicone |
| Model Name | Crackle’n Kracken Popp’n |
| Model Number | KK020 |
| Number of Items | 1 |
| Occasion | Birthday |
| Scent | Unscented |
| Set Name | Thinking Putty |
| Size | Small |
| Theme | Fantasy |
| UPC | 810066953680 |
| Unit Count | 1.0 Count |
R**M
Buy it!
My kids are absolutely obsessed with this putty. The texture is perfect - stretchy, squishy, and super satisfying to play with. It keeps them entertained for long stretches, and I love that it doesn’t dry out or make a mess. Great quality and totally worth it if you’re looking for a simple toy that kids actually keep coming back to.
T**A
A gift for myself i fidget a lot due to my anxiety and ADHD
First of all it took me the longest time ever to get the container open, but after I finally got it open it was cool it really doesn’t crack a lot like advertised. But it is something nice to squeeze and play with while you watch tv or listen to music or just do whatever. It also really hard sometimes to pull apart and squeeze. I know they said it’s made out of tough material and it never drys out. They’re some other Thinking putty that I saw on the Crazy Aaron’s page that I was thinking of made trying out down the road
B**9
Perfect for ADHD Fidgeting
Therapist stamp of approval! I got this for my kids at the recommendation of their counselor. Awesome texture, fun sounds, the perfect amount of stimulation. Keeps them from picking things and helps keep their focus when needing to do unpleasant tasks. Doesn't smell like playdoh, or leave grease stains like sticky hands. The best part? I ordered one and received 6! Thank you!!
S**E
Nice but No “crackles, & pops” :(
I am a fan of Crazy Aaron’s Thinking Putty! The color, texture and “strength” of this putty is excellent! I however thought this version would have extra “crackles, & pops” to it, which is my ASMR!, but it really doesn’t have any at all unfortunately. My “mixed emotions” thinking putty snaps and crackles so much more than this version. Would recommend otherwise!
M**T
Fun for kids without the mess.
Bought this for my 5 year old grandson. He has wanted slime but makes a mess with it. This isn't the same ad slime but is nice to shape and manipulate without getting it all over. It is thicker and somewhat harder than slime.
M**.
Not worth it. Styrofoam beads fall out!
My biggest issue with this product is the white styrofoam beads pop out and fall away when you are doing the best bit… hearing the putty snap and pop. Also mine did not come with many beads, maybe it was a mistake? After a few uses I was tired of hunting down all the styrofoam balls and cleaning them off so no debris was added to the mix. I really was looking forward to this for work, but it’s too much hassle.
P**H
It lasts
Kids love it. They all play with it ages 2 to 14.....it stays on the table 24/7 and everyone picks it up
R**A
Does not pop and crackle.
This is my 3rd purchase of Crazy Aaron's Putty. While I think it's overpriced, I really enjoy playing with it at work. It's oddly satisfying, de-stresses me, and keeps me occupied as I'm on the phone a lot and frequently on hold for long periods of time. The reason I gave this one only 1 star is because I am soooo disappointed in the fact that it does not pop and crackle as described. I don't like the looks of this one....it's not pretty like the others I bought. I only bought it because the description says it pops, crackles, & snaps. It stopped making these noises within the first 2 or 3 minutes of use. Had I known that it really didn't pop & crackle much at all, I would have bought one that was much prettier to look at instead. I should return it, but I hate returning things.
M**.
There were only five white balls in the putty. Did not pop at all. Was not as advertised.
D**.
This is really sticky. Definitely do not get on clothes of any kind, paper, and hair. It does not come off. Also it does not pop. For all my trying I have only had it pop twice. It does work well as a hand and forearm strengthener.
M**.
I bought this putty along with another one from the same brand. I was intrigued by the description about it “crackling”, but was disappointed when I received it and realized it didn’t really “crackle”. I think that’s what the tiny styrofoam balls are meant to do, but I can’t say they really add that effect. In fact, I think they’re more prone to falling out of the putty. Wouldn’t buy this specific putty again, but their other putties are good.
Trustpilot
2 weeks ago
1 month ago